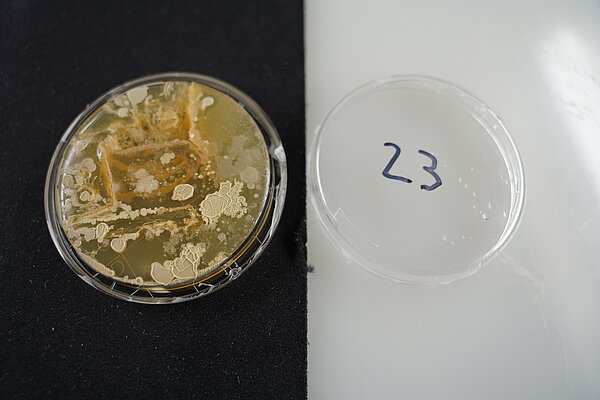
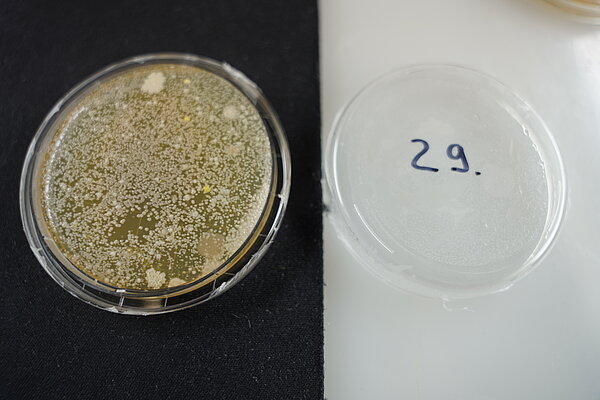

The MicroPop Microbiome MUT
During the vernissage of "MicroPop - Design, Science and the World of Microbes" at Museum der Universität Tübingen MUT, guests had the opportunity to take samples from surfaces to make invisible things from our everyday life visible.
Making the microbiome of the Museum der Universität Tübingen MUT visible to create a direct link to our own environment was the idea of Franziska Höhn (CMFI) and David Paccagnella, PhD students from the University of Tübingen. The guests of the exhibition were given so-called contact plates by them in the microbiological laboratory, which had been set up especially for the exhibition. Contact plates are small Petri dishes with a nutrient medium (agar) on which microorganisms find excellent growth conditions.
The idea attracted great interest and guests began taking samples throughout the building. The surfaces used ranged from the walls and floors of the museum to smartphones, shoes, bags, and body parts such as cheeks, tongues, and palms. After the samples were made, the contact plates contained microorganisms that we allowed to grow in an incubator at warm, humid temperatures for five days. Together the samples give a picture of the microbiome of the Museum der Universität Tübingen MUT on June 29, 2023 (the numbers allow anonymous identification of the own sample).
Exhibition Dates and Venues

April 24 – 28, 2023
Tue – Fri | 12 p.m. – 7 p.m.
Stuttgart State Academy of Art and Design
Neubau 2, Foyer
Am Weißenhof 1
D-70191 Stuttgart

May 6 – June 15, 2023
Thu – Sun | 2 – 8 p.m.
SpeicherART at DER SPEICHER GRAMZOW
Am Bahnhof 5, D - 17291 Gramzow/Uckermark

June 29 – August 27, 2023
Wed – Sun | 10 a.m. – 5 p.m.
Thu | 10 a.m. – 7 p.m.
Museum der Universität Tübingen (MUT) | Ancient Cultures | Hohentübingen Castle
Burgsteige 11, D - 72070 Tübingen
The exhibition “MicroPop - Design, Science and the World of Microbes” shows exhibits that reflect the invisible world of microbes in an artistic way and make it tangible. It invites us to reflect on our relationship with these small living creatures and allows us to explore new perspectives and approaches that arise when science and design come together.
The Idea of the Project
About 40 to 100 trillion microorganisms live on and in every human body. Together, all these bacteria, viruses, fungi and other microbes make up our individual microbiomes. Today, research into how exactly they interact and how their complex micro biotical balance works is more important than ever: a better understanding of the microbiome can help us, for instance, to get a better grip on known and emerging infectious diseases. This is crucial, especially in light of increasing antibiotic resistances around the world.
The exhibits are the result of a collaboration launched in November 2021 between the University of Tübingen's Cluster of Excellence "Controlling Microbes to Fight Infections" (CMFI), the Stuttgart Academy of Fine Arts (ABK), and the Tübingen Research Center for Science Communication. This page presents a first look at our results.
More about the project
Leon Kokkoliadis
Public Relations
Tel: +49 7071 29-74707
E-Mail: leon.kokkoliadis@uni-tuebingen.de